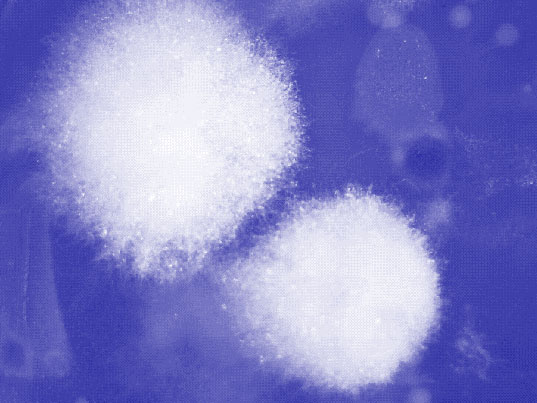

산책자의 흔적은 공간에 대한 살아있는 기억을 통해 새롭게 현재를 감각하려는 시도다.
우리는 인천을 걷는다. 마주할 것들을 정확히 알지 못한 채. 다만 어떤 사건을 조우하거나 그 앞에 다다르기 위해. 공간이 담은 무수한 기억들과 몸으로 부딪친다. 우리에게 닿은 공간의 기억들은 미생물 흔적으로 남는다. 우리는 이들을 또다른 공간인 배양접시에 옮기고, 이들이 잠재 상태에서 활발하게 성장할 수 있도록 배양한다. 공간과 마주한 우리의 기억, 그리고 공간에 잠재된 기억이 살아있는 현재가 되도록 한다.
몸이 존재하는 지금 여기엔 우리가 감각하지 못하는 다른 무언가의 시간 또한 함께 있다. 키보드 자판에도, 아침 식사에도, 우리가 인식하는 모든곳에. 적합한 때를 기다리는, 번거로운 수고 없이는 쉬이 볼 수 없는 어떤 접촉의 기억이 존재한다. 예를 들어 옷에 곰팡이가 피었다면 이것은 분명 우리가 모르는 새, 무언가가 언젠가 옷에 닿았다는 것이다. 그러니까, 이들은 우리 눈에 보이지 않는 때에도 이미 판독할 수 없는 기억과 시간을 담고 있다. 그렇게 이들은 계속해서 현재를 살아간다. 이들은 각자의 기억에서 뻗어나가는 무수한 잠재성을 지닌 과거이자 현재, 이 순간으로 존재한다.
Traces of walkers are an attempt to sense the present anew through a living memory of space.
We walk through Incheon.
Not knowing exactly what we will encounter. We bump into the representatives of the space with our bodies, and they touch us, leaving microbial traces. We incubate those traces, which are latent in space, becoming a living present.
As long as there is substance, there is also a time of something else that we are unable or unwilling to sense. On the keyboard, at breakfast, everywhere we recognize ourselves, there are memories of contact that are waiting for the right time to manifest themselves, memories that we can’t easily see without going through the trouble. For example, if your clothes are mildewed, it’s because something unrecognized touched them at some point. In other words, they already contain unreadable memories and time, even at the point of invisibility, before the manifestation in which we find them, and they continue to live on. At the same time, they exist as a past, a present, and this moment, with myriad potentials stretching out from their respective memories.